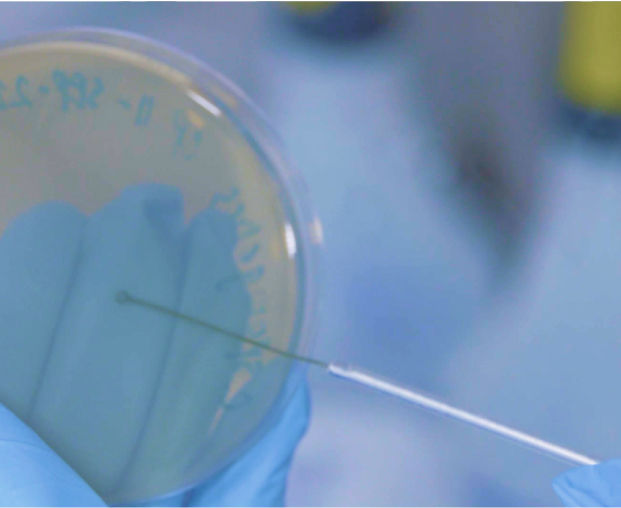
Close up of agar plate
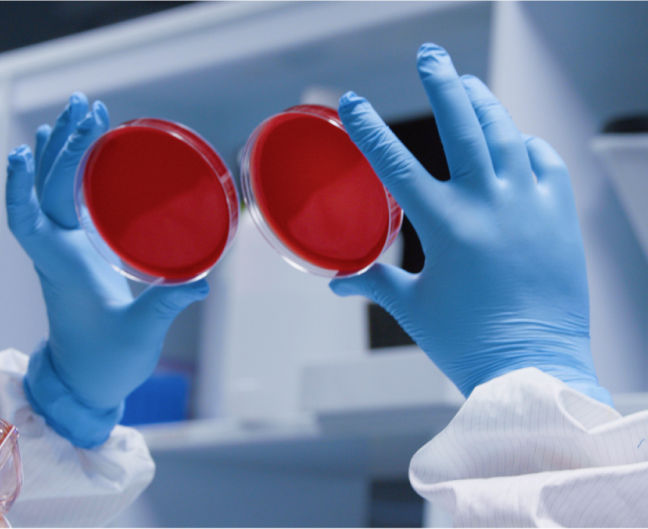
Inspecting agar plates in QC lab
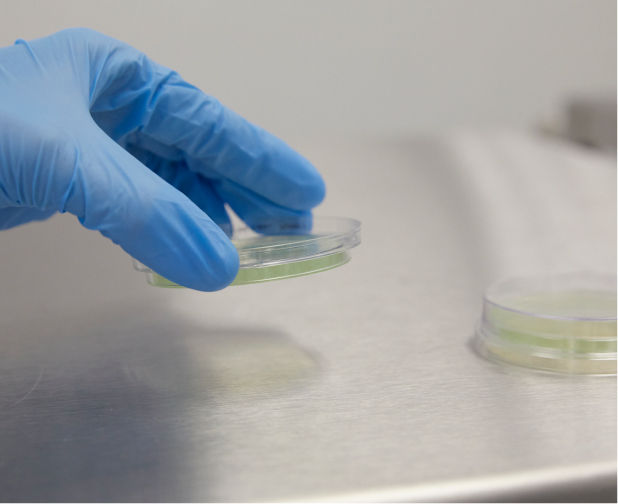
Close up of gloved hand touching contact plate to surface for environmental monitoring
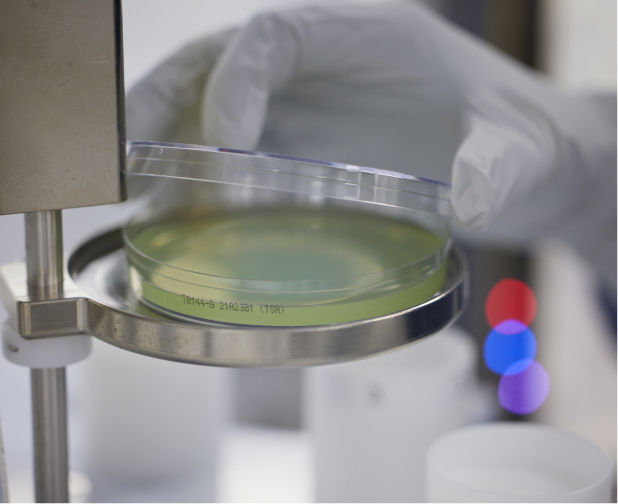
Close up of green agar plate in cleanroom being used for environmental monitoring
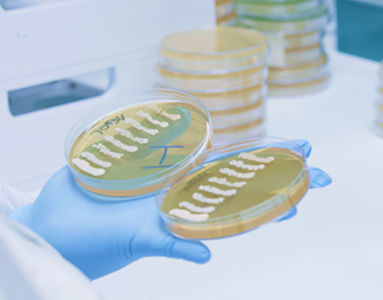
Close up of agar plates in gloved hand for quality control testing
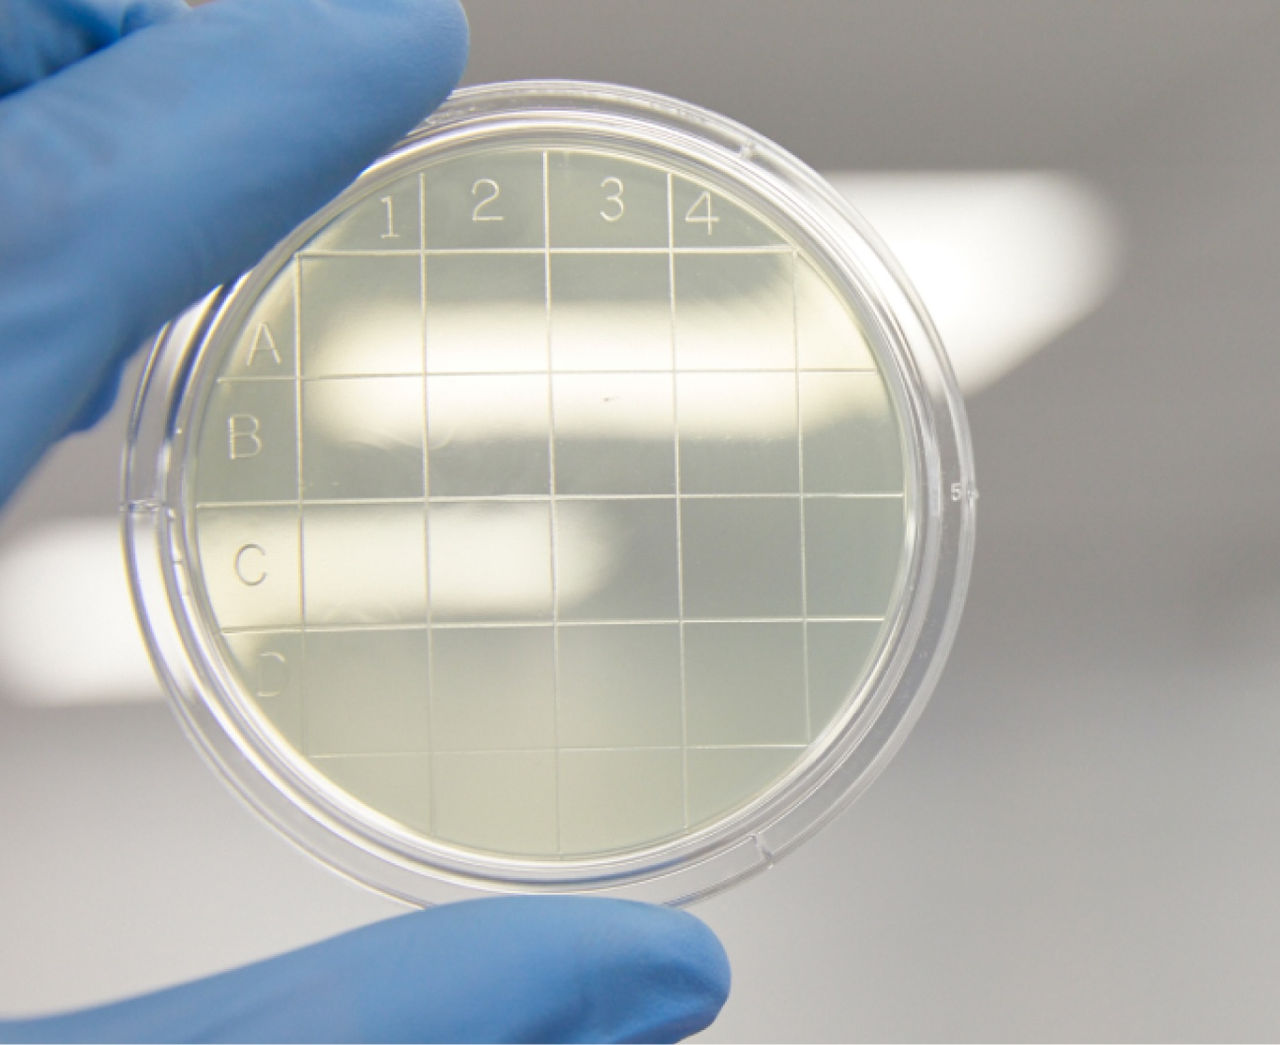
Contact plate held up to the light

Home
We've been making solutions possible since 1996.
It started with a Genentech scientist and a simple idea: custom reagents should be as fast and reliable as anything off the shelf. Thirty years and 180,000 sq. ft. of ISO 13485-certified manufacturing later, that idea is still driving everything we do for our 3,000+ customers working across the life sciences. See how we got here.

We just found 35% in your WFI Quality Water budget
To help you save on costs while getting a container format that matches your process needs, we now offer two configurations of our 200 L WFI Quality Water. For workflows that don't require an integrated dip tube, our new standard configuration has a meaningfully lower price per unit without any compromise on water quality or compliance.

Learn how to use the PluriFreeze™ Cryopreservation System in a closed workflow
We've updated the protocol for the PluriFreeze Cryopreservation System to provide more detailed instructions for a wider variety of use cases, including large-scale cryopreservation in a closed system, which is facilitated by PF10's low viscosity.

Have you read our new white paper?
Streamlining the Transition from RUO to GMP:
Key Process Development Considerations to Accelerate Scale-Up and Tech Transfer for Emerging Therapies

Get to know our quality control testing
We follow rigorous testing and documentation procedures that go beyond industry standards to ensure you get reproducible results. Our industry-trained experts can also help design a custom testing program to meet your specific requirements.

Streamline your scale-up with single-use bags
Did you know that our RUO and GMP buffers, broths, and water are available in bag sizes ranging from 1 L to 200 L? This is just one of the flexible format options we offer to help support your tech transfer and clinical manufacturing needs.

New product: Environmental monitoring settle plates
You can now find Tryptic Soy Agar Settle Plates in our online catalog. Designed to be your first line of detection of microbial contamination, these are the same high-quality plates we use to perform environmental monitoring in our own cleanrooms.

Discover our new custom services
We are now offering a RUO+ manufacturing grade to streamline your transition from RUO to GMP, as well as Express•Tek℠ Production services to get your custom formulation into production in days instead of weeks.

- Timeline Tout
- Video
- WFI
- Pluristyx
- White Paper
- QC testing
- Bags
- Environmental monitoring
- Custom services
See why thousands of scientists trust our products
Explore our vast citations library to see peer-reviewed studies from researchers who have relied on our products
to deliver results across a wide range of life science applications. Find research relevant to your work and see exactly what
results you can expect in your specific workflow.
- Culture
- Cryopreservation
- Extraction and Purification
- Analytics
- Environmental Monitoring
A trusted partner that
can help you scale
With 30 years of experience manufacturing custom reagents, we have finessed the rapid turnaround of customer-specified products. Our new state-of-the-art facility has increased our footprint to over 180,000 square feet, enabling us to better serve our customers by providing the scale and flexibility needed for GMP manufacturing.
Find out what’s possible
Talk to our consultants today to find the ideal off-the-shelf or custom solution that can help you achieve your goals.
Our team is here to help
Monday to Friday
8:00AM–5:00PM PT
- AAV Workflow
- Plasmid Workflow
Find out what’s possible
Talk to our consultants today to find the ideal off-the-shelf or custom solution that can help you achieve your goals.
Our team is here to help
Monday to Friday
8:00AM–5:00PM PT
Where to find us
For your convenience, we work with a global network of distributors.
You'll always find the widest selection of our products right here, but you can also order our off-the-shelf solutions from our distributors.
- AAV Workflow
- Plasmid Workflow
Bridge the gap from RUO to GMP with
our range of manufacturing grades
Find out what’s possible
Talk to our consultants today to find the ideal off-the-shelf or custom solution that can help you achieve your goals.
Our team is here to help
Monday to Friday
8:00AM–5:00PM PT
We'll come to you
Want to learn more about what we can do for your company?
Schedule a time for our team to come give a tailored presentation about how our products and services can address your specific needs.
- Acids and Bases
- Additives
- Alcohols
- Culture Media
- Buffers
- Detergents and Surfactants
- Salts
- Sugars
- AAV Workflow
- Plasmid Workflow
Find out what’s possible
Talk to our consultants today to find the ideal off-the-shelf or custom solution that can help you achieve your goals.
Our team is here to help
Monday to Friday
8:00AM–5:00PM PT
Take a tour of our facilities
Come see our state-of-the-art facilities in person.
Schedule a tour to get an in-depth understanding of our manufacturing capabilities. Our QMS and production experts can answer your detailed questions and discuss how we can meet the needs of your specific application.